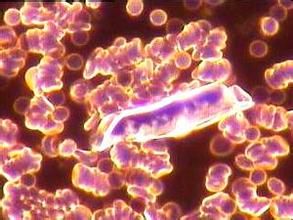
膽固醇結晶

膽固醇結晶

膽固醇結晶(cholesterolcrystals)在尿沉澱物中很少見膽固醇結晶,如有則多在尿液表面成薄片狀,膽固醇結晶形態為缺角的長方形或方形,無色透明,可溶於氯仿、乙醚。膽固醇結晶可常在乳糜尿中看到,偶亦見於膿尿中。膽固醇是不溶於水的.在膽汁中它以溶於與膽汁酸、卵磷脂所形成的微膠粒中運載的。任何原因造成膽汁中膽固醇含量增多和或膽汁酸、卵磷脂含量減少.致使膽固醇濃度相對增高,就可使膽固醇從膽汁中析出結晶而形成結石。膽固醇結晶體如果存在於血液當中,它像石頭、玻璃一樣非常堅硬、鋒利,很容易劃破血管造成腦出血,還會引發冠心病、中風。平時飲食不注意,比如吃的:雞蛋、魷魚、燒烤、油炸食品、動物內臟、豬手、豬、牛、羊肉等它們含有大量的膽固醇,身體消化不了就會變成膽固醇結晶。
基本信息
- 中文名:膽固醇結晶
- 英文名:cholesterolcrystals
- 注意:可溶於氯仿、乙醚
- 相關描述:可常在乳糜尿中看到
析出原因
 膽固醇結晶脂溶性的膽固醇靠著膽汁酸和磷脂的幫助,能夠完全溶解在膽汁中,不會有膽固醇結晶析出。但是,膽汁酸和磷脂溶解膽固醇的能力有一定限度,也就是說一定量的膽汁酸和磷脂只能使某一定量的膽固醇溶解。如果膽汁中的膽固醇含量超過了膽汁酸和磷脂溶解膽固醇的能力,膽汁中部分膽固醇就不能溶解在膽汁中,就會析出膽固醇結晶而發生沉澱。析出的膽固醇結晶相互聚結,久而久之便會形成膽固醇結石。科學家們把膽固醇的含量接近膽汁能夠溶解它的能力的膽汁叫飽和膽汁,而將膽固醇含量超過膽汁能夠溶解它的能力的膽汁稱為過飽和膽汁。飽和膽汁和過飽和膽汁的形成是膽固醇結石形成的首要條件。近年來各國的科學家對這一問題作了廣泛深入的研究。結果發現膽固醇結石病人從肝臟分泌出來的膽汁就是飽和或過飽和膽汁,故這些病人的肝膽汁已經具有形成結石的初步條件。膽汁的化學成分分析表明,膽結石病人的膽汁有膽固醇含量的明顯增高,或有膽汁酸和磷脂含量的明顯降低。因此,肝臟分泌過多的膽固醇或產生膽汁酸和磷脂過少,均會導致飽和或過飽和膽汁的產生。
膽固醇結晶脂溶性的膽固醇靠著膽汁酸和磷脂的幫助,能夠完全溶解在膽汁中,不會有膽固醇結晶析出。但是,膽汁酸和磷脂溶解膽固醇的能力有一定限度,也就是說一定量的膽汁酸和磷脂只能使某一定量的膽固醇溶解。如果膽汁中的膽固醇含量超過了膽汁酸和磷脂溶解膽固醇的能力,膽汁中部分膽固醇就不能溶解在膽汁中,就會析出膽固醇結晶而發生沉澱。析出的膽固醇結晶相互聚結,久而久之便會形成膽固醇結石。科學家們把膽固醇的含量接近膽汁能夠溶解它的能力的膽汁叫飽和膽汁,而將膽固醇含量超過膽汁能夠溶解它的能力的膽汁稱為過飽和膽汁。飽和膽汁和過飽和膽汁的形成是膽固醇結石形成的首要條件。近年來各國的科學家對這一問題作了廣泛深入的研究。結果發現膽固醇結石病人從肝臟分泌出來的膽汁就是飽和或過飽和膽汁,故這些病人的肝膽汁已經具有形成結石的初步條件。膽汁的化學成分分析表明,膽結石病人的膽汁有膽固醇含量的明顯增高,或有膽汁酸和磷脂含量的明顯降低。因此,肝臟分泌過多的膽固醇或產生膽汁酸和磷脂過少,均會導致飽和或過飽和膽汁的產生。 如何消除
膽囊結晶主要是膽汁成分沉澱出來了,還沒有繼續長大形成大的結石,這種情況主要是注意飲食和生活習慣了,首先是不要吃油膩高脂肪的食物,其次就是三餐一定要及時吃,尤其是早餐預防膽結石很重要的。 膽固醇結晶
膽固醇結晶
膽固醇結晶
膽固醇結晶